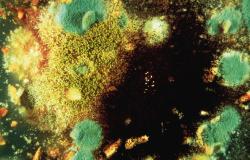

One Health, une seule santé

Une seule santé, pour la Terre, les animaux et les Hommes
One Health, « une seule santé ». Ce concept, initié au début des années 2000, fait suite à la recrudescence et à l'émergence de maladies infectieuses, en raison notamment de la mondialisation des échanges. Il repose sur un principe simple, selon lequel la protection de la santé de l’Homme passe par celle de l’animal et de leurs interactions avec l’environnement. La santé animale, végétale, la santé de l’environnement et celle des humains sont donc intimement liés. C’est le cas par exemple lorsque l’on soigne des animaux d’élevage avec des antibiotiques. Cela entraine des résistances transmissibles aux bactéries présentes dans notre microbiote, celui des animaux ou dans l’environnement. C’est le cas également de l’utilisation d’insecticides, tel que le chlordécone, qui utilisé au départ pour protéger les cultures de bananiers d’un insecte ravageur, contamine les sols, les eaux souterraines, les rivières, mais aussi les animaux élevés en plein air et in fine expose les humains à des molécules néfastes pour leur santé. Quelles solutions ? Face à la complexité et aux interconnections entre santé des animaux, des Hommes et leur environnement, c’est le système dans son intégralité qui est à repenser. C’est ce que les scientifiques d’INRAE s’attachent à faire en menant des travaux interdisciplinaires associant biologie, écologie, mathématiques, économie et sciences sociales et en expérimentant de nouveaux systèmes respectueux de toutes les dimensions de la santé, y compris la santé de notre environnement, une vision élargie de One Health que certains appellent désormais Eco Health.

Dossier revue Ressources
Les maladies infectieuses sans frontièresDepuis quelques décennies, des maladies infectieuses se sont répandues sur le globe. Parmi elles, les zoonoses soulignent le lien de plus en plus étroit entre humains, animaux domestiques, animaux sauvages et environnements perturbés. L’approche « une seule santé » (One Health) intégrant santés humaine, animale et environnementale s’impose aujourd’hui comme la voie indispensable pour s’armer face à ces fléaux.
Biodiversité et santé PREZODE, une initiative internationale inédite pour prévenir de futures pandémies
Lancé lors du One Planet Summit sur la biodiversité, en janvier 2021, à l'initiative d'INRAE, de l'IRD et du Cirad, PREZODE place la recherche en santé animale, humaine et environnementale au cœur des efforts mondiaux nécessaires pour mieux comprendre, prévenir, surveiller et détecter à temps les risques de pandémies zoonotiques. L'initiative est désormais portée par près de 170 partenaires, dont 14 gouvernements.

Documentaire ARTE : Epidémies, l'empreinte de l'homme
Ce documentaire nous emmène en Guyane pour découvrir les travaux de Jean-François Guegan, infectiologue à INRAE, avec une équipe internationale, sur l'émergence de l'ulcère de buruli : voir à 49'45.
Film, 97 minutes. Diffusion TV : 11 novembre, 23 h 15. A revoir en VOD.
L'alimentation au coeur de notre santé
« Ce que tu manges te constitue de l’intérieur, et ce que tu manges dessine ton monde extérieur ». L’alimentation est à la fois centrale pour notre santé et détermine, via nos choix de régimes alimentaires, la production agricole et ses impacts sur l’environnement dont l’état influence aussi notre santé. L’alimentation est ainsi au cœur des enjeux de santé globale, un sujet traité dans la prospective scientifique « Nexus Santé : entre Agriculture -Alimentation – Environnement »
Deux dossiers de presse

> One Health, une seule santé pour la Terre, les animaux, et les hommes
inrae-dp-one_health-web.pdf pdf - 1.11 MB> Consulter le dossier de presse et la vidéo de conférence de presse du 8 juillet 2020
SOMMAIRE
> La mondialisation des échanges favorise la circulation des pathogènes >>>
> Quand la santé des animaux impacte celle des Hommes >>>
> Eco Health, la santé de l’environnement clé de voute de la santé globale >>>
> La nature, pourvoyeuse de solutions >>>
> Rester vigilant et expérimenter de nouveaux systèmes >>>

> Quelles recherches pour accompagner la transition vers des systèmes alimentaires sains et durables ?
Systèmes alimentaires sains et durables pdf - 1.82 MB> Consulter le dossier de presse et la vidéo de conférence de presse du 9 novembre 2020
> Du champ à l'assiette, de nombreux leviers d'action pour des bénéfices santé >>>
> Modes de consommation, régimes alimentaires :
quels impacts sur la santé ?
et sur l'environnement ?
> Accompagner la transition à travers les politiques publiques >>>

Sciences en questions
Une seule santé. S'ouvrir à d'autres savoirsOne Health nous engage aujourd’hui à une réflexion sur l’intégration d’autres formes de savoirs en santé, notamment ceux issus des communautés locales. En s’appuyant sur ses terrains d’enquête situés en Asie, Nicolas Lainé montre que les savoirs locaux sont dynamiques et en constante recomposition.
La mondialisation des échanges favorise la circulation des pathogènes

> Concilier les échanges internationaux et la sécurité des consommateurs
Nous consommons de nombreux produits importés. Cela répond à un souhait de diversité dans l'assiette des consommateurs, mais cela pose la question de la sécurité sanitaire de ces aliments. Quel équilibre trouver entre assurer la sécurité sanitaire des aliments, ne pas entraver les échanges internationaux, et éviter toute dérive protectionniste ?

> Covid-19 : la santé globale en jeu
La pandémie liée à la Covid-19 illustre les liens entre santé des animaux, santé de l'environnement et santé humaine. Le point sur nos recherches.
Eco Health > la santé de l'environnement au centre de la santé globale
Les activités humaines peuvent impacter durablement les écosystèmes, et en retour affecter la santé des populations, qui dépendent pourtant des ressources de la Terre. Les enjeux sont immenses et visent à concilier la nécessité de nourrir les hommes avec l’obligation de préserver l’environnement dans lequel eux-mêmes, mais aussi l’ensemble des organismes vivants, évoluent.

Quand la santé des animaux impacte celle des Hommes

> Homme, animal, environnement : tous concernés par l'antibiorésistance
La résistance des infections bactériennes aux antibiotiques se développe avec leur usage. Elle se construit au gré de mécanismes qui se transmettent par l’environnement et l’alimentation et affectent l’homme et l’animal. Des recherches interdisciplinaires et des solutions fondées sur une meilleure compréhension de l'animal et des pathogènes dans leur environnement.
> Rongeurs et pathogènes : un monde d’interactions
Le projet européen BiodivERsA-BioRodDis, piloté par INRAE, porte sur liens entre biodiversité et santé, et explorent l’influence de la biodiversité sur la dynamique des pathogènes, en forêt et dans les parcs urbains. Les scientifiques s’intéressent en particulier aux rongeurs, susceptibles de véhiculer une importante variété d’agents pathogènes à l'origine de maladies chez l'Homme.

> DOSSIER : Les tiques, vecteur important de maladies animales et humaines
Dans le monde, les tiques sont le 1er vecteur de maladies chez l’animal et le 2e pour l’Homme. C'est le cas également chez les animaux d'élevages et les animaux domestiques (chien, le chat ou le cheval). Certains animaux sauvages (chevreuils, rongeurs, oiseaux) sont des sources de repas sanguin pour les tiques et constituent des réservoirs pour les agents pathogènes transmis par les tiques. C’est donc un continuum animal-homme-environnement qu’il faut étudier dans une approche systémique, qui est développée dans le concept « One health ».

> Prévenir et guérir la Cryptosporidiose
La Cryptosporidiose est une maladie intestinale grave chez l'enfant, les patients immunodéprimés et les ruminants. Les chercheurs d'INRAE ont identifié deux stratégies pour lutter contre cette maladie parasitaire : interrompre le développement du parasite et renforcer l'immunité de l'hôte.
Eco Health, la santé de l’environnement clé de voûte de la santé globale

> Prendre en compte les effets des pesticides dans les procédures réglementaires
Ces dernières années ont été marquées par la montée des controverses liées à l’impact des pesticides sur la santé et l’environnement. Une étude récente d'INRAE met d'ailleurs en avant l'effet cocktail des pesticides sur des rats. Les procédures d’autorisation de leur mise sur le marché posent également question : comment améliorer la prise en compte des effets des pesticides sur la santé et l’environnement dans les procédures réglementaires ?

La chlordécone, un poison pour longtemps
La chlordécone, un insecticide utilisé massivement en Guadeloupe et Martinique jusqu’en 1993, pour lutter contre le charançon du bananier, a contaminé les sols, les eaux souterraines, les rivières et le littoral marin. Aujourd'hui encore les animaux d'élevage sont contaminés via leur alimentation (fourrage, sol) et peuvent ainsi entraîner des risques de contamination chez l'Homme.
> L'étude sans fin des mycotoxines
Les mycotoxines sont des toxines produites par des champignons tels que les moisissures et peuvent avoir de graves conséquences sur la santé des animaux ou des Hommes qui les consomment. Plus de 1 000 sortes ont été identifiées et les chercheurs d'INRAE ont montré que la toxicité cumulée de plusieurs mycotoxines, est supérieure à la somme des toxicités de chacune d’elles. Eviter les contamination est donc un enjeu important pour notre santé.

> « Forêt », « déforestation » et « maladies émergentes » : l’arbre qui cache la forêt !
La pandémie mondiale de Covid-19 met en lumière l’importance de certains domaines scientifiques jusque-là peu étudiés, comme le lien entre les écosystèmes, leur biodiversité et l’émergence de nouvelles maladies infectieuses. En effet, les humains exploitent de plus en plus leur environnement et sont par conséquent plus exposés à certains microbes, ce qui peut accroître les risques de nouvelles contaminations. Quel est le lien entre la déforestation et l’émergence de maladies ? Où en est la science sur ce sujet ?

> Les richesses insoupçonnées du sol
Un gramme de sol contient un milliard de bactéries, de cent mille à un million d’espèces différentes. A ce titre, le sol constitue l’un des plus grands réservoirs de biodiversité et de ressources génétiques de notre planète. Mais avec d’importantes disparités, qui dépendent notamment de l’usage qu’on en fait. Or, perdre de la biodiversité nous prive d’espèces capables de dégrader les polluants et favorise l’émergence de bactéries pathogènes qualifiées de stratèges opportunistes, qui sont promptes à oloniser les environnements perturbés...
La nature, pourvoyeuse de solutions

> La structure du paysage, alliée de la lutte naturelle contre les ravageurs
Bois, haies, bandes enherbées... la structure du paysage influence la présence des ravageurs mais aussi celle de leurs ennemis naturels, les auxiliaires de culture. Une piste à privilégier : organiser les parcelles à la manière d’une mosaïque et développer une plus grande biodiversité cultivée.

> DOSSIER - Agriculture compétitive et durable : les apports croissants du biocontrôle
Comment remplacer les produits phytosanitaires pour protéger les cultures des bioagresseurs qui les menacent ? Une des stratégies envisagée est le biocontrôle. Il s'agit d'un ensemble de méthodes de protection des cultures basées sur l’utilisation d’organismes vivants ou de substances naturelles.

> La diversité, source de résilience
La diversité des microrganismes, que ce soit celle qui se développe autour des racines dans le sol ou celle des microbiotes des animaux, est une véritable source de résilience des agroécosystèmes mais aussi une source de... bonne santé !

> Les phages, de puissants alliés contre les bactéries
La phagothérapie consiste à utiliser les phages, qui sont des virus qui n’infectent que les bactéries. Si les premiers usages de ces auxiliaires à des fins thérapeutiques remontent aux années 1920, ils sont tombés en désuétude après la découverte des antibiotiques. Notamment parce qu’au contraire de ces derniers, ils sont super spécialisés, ciblant souvent une seule espèce de bactéries. Pourtant, leur efficacité est redoutable, comme l’ont démontré récemment des chercheurs d’INRAE.

> Pour que durent les résistances
Les interactions entre un hôte et ses pathogènes font appel à des mécanismes très complexes, que les chercheurs s’attachent à décrypter. Cette étape est essentielle pour développer des méthodes de lutte contre les bioagresseurs, et pour aider la plante ou l’animal à se défendre plus efficacement, en gardant une longueur d'avance sur la capacité d'adaptation de leurs pathogènes qui peut leur permettre de contourner la résistance des plantes.
Rester vigilant, expérimenter de nouveaux systèmes

> A la vigie des épidémies et des risques sanitaires
Surveiller pour anticiper les risques et les prévenir... Certains analysent des données, d’autres s’intéressent à des molécules ou observent des êtres vivants. Mais tous les acteurs impliqués dans les projets One Health, partagent leurs travaux, leurs ressources, leurs questionnements, dans le but d’apporter des éléments de réponse concrets aux problèmes de santé présents et à venir.

La sentinelle de l'eau...
Ce petit crustacé est devenu en quelques années la coqueluche des agences de l’eau. Le gammare est en effet une formidable sentinelle du milieu aquatique. Les chercheurs ont mis au point une technique innovante de biosurveillance, basée sur l’utilisation de gammares élevés en environnement contrôlé, puis calibrés, triés et conditionnés par la société Biomae, essaimage du Laboratoire d’écotoxicologie d’INRAE.
Expérimenter à l'échelle du système

Face à la complexité des intéractions entre la santé des animaux, des Hommes et de l'environnement, il est nécessaire de penser les solutions à l'échelle du système. Pour cela INRAE est doté de plusieurs stations expérimentales qui testent grandeur nature les systèmes de production de demain. Focus sur trois d'entres elles :
-
Un verger pionnier avec moitié moins de pesticides
Dans la Drôme, INRAE et ses partenaires mènent depuis 2004 une expérimentation pionnière pour réduire l’utilisation des pesticides en vergers de pommiers. Dans les systèmes les plus économes en pesticides, la réduction atteint 50 %. - Mirecourt : 10 ans d'expérimentation de systèmes d'élevages bio
Située dans la plaine des Vosges, l’installation expérimentale de Mirecourt conduit depuis 2004, en parallèle et avec une démarche pas à pas, deux systèmes d’élevages bio qui minimisent le recours aux intrants (zéro engrais, zéro pesticide, zéro paille extérieure, minimum de fioul) : l’un 100 % herbager et l’autre en polyculture-élevage. - Plateforme CA-SYS : expérimenter des systèmes agroécologiques innovants et durables
Ce dispositif en grandes cultures renouvelle les méthodes expérimentales en combinant sélection variétale, minimisation des intrants, valorisation des interactions biologiques et organisation de l’espace agricole.
L’alimentation au cœur de notre santé
L’alimentation est au centre d’un système complexe. Ce que l’on mange impacte évidemment notre santé, déjà du fait de la qualité nutritionnelle des aliments mais aussi du fait de la présence parfois de contaminants ou molécules néfastes à notre santé (nitrites, bisphénols, salmonelles, etc.) dans les aliments consommés. Aussi, le choix de nos régimes alimentaires impacte la santé de l’environnement. Par exemple, un régime alimentaire avec une consommation de viande élevée a un impact plus négatif sur l’environnement en terme d’émission de gaz à effet de serre qu’un régime avec moins de viande et davantage de protéines végétales. L’étape de la transformation a également son lot de divers impacts sur les aliments, notre santé et celle de l’environnement : expliquer. C’est l’ensemble du système alimentaire avec ses multiples interactions (parfois antagonistes) qu’il convient d’étudier. Quelques exemples de travaux d’INRAE l’illustre :

> Comment les modes de production influent-ils sur la qualité des produits ?
Le lait des vaches qui ont le loisir de ruminer l’herbe des pâturages présente des différences de composition majeures par rapport à celui des vaches nourries au concentré et à l’ensilage de maïs. Le lait des premières est plus riche en vitamine A et en acides gras insaturés (oméga 3), celui des secondes contient plus d’acides gras saturés tels que l’acide palmitique, qui, consommés en excès, favorisent l’apparition des maladies cardiovasculaire.

> Contaminants alimentaires : la recherche appuie sur l’accélérateur
Pesticides sur les pommes, perturbateurs endocriniens dans les emballages plastiques, composés perfluorés dans le revêtement des poêles, métaux lourds dans la chair des poissons, PCBs dans la viande : la nourriture nous expose sournoisement aux contaminants. Les chercheurs INRAE tentent de mieux comprendre les mécanismes par lesquels les contaminants affectent notre santé. Deux grands projets de recherche débutent en 2020, et feront entrer dans la toxicologie des aliments des méthodes révolutionnaires.
Voir aussi : les résultats de l’expertise scientifique collective sur la qualité nutritionnelle des aliments d’origine animale >>>
> Vers un régime alimentaire plus durable ?
Si le régime alimentaire doit avant tout être sain et couvrir les besoins nutritionnels, il doit aussi être culturellement acceptable, économiquement accessible, avec un impact réduit sur l'environnement. Les chercheurs ont identifié parmi la grande diversité des régimes celui qui réalise le meilleur compromis entre la qualité nutritionnelle et un impact moindre sur les émissions de GES.
Des politiques publiques pour accompagner la transition vers des systèmes alimentaires sains et durables

> Des recommandations pour une meilleure alimentation en Outre-mer
L’expertise « Alimentation et nutrition dans les départements et régions d’Outre-mer » a permis de réaliser un état des lieux de la situation nutritionnelle des populations dans les Outre-mer dont l’évolution des modes de vie peut conduire à une activité physique insuffisante et une alimentation déséquilibrée. En effet, les départements et régions d’Outre-mer (Drom) font face à des prévalences plus élevées de surpoids, d’obésité et de diabète que dans l’Hexagone. Les experts proposent 24 recommandations d’actions et des dispositions spécifiques pour orienter les politiques publiques de nutrition.

> Nutri-Score : un levier pour la qualité des achats
Le Nutri-Score est un système d’étiquetage basé sur la composition nutritionnelle des produits. L’objectif ? Aider les consommateurs à identifier de façon simple et rapide la qualité nutritionnelle des produits et orienter leurs achats. Un bon exemple de politique publique mise en œuvre pour améliorer l’alimentation.

> Des taxes pour garder la santé
Pour lutter contre les boissons sucrées, dont on connait les effets nocifs sur la santé, une quarantaine de pays, dont la France, ont choisi la voie de la fiscalité. Généralement, la stratégie a payé : les taxes ont bien réduit la soif des consommateurs pour ces boissons. Mais les économistes d’INRAE de l’Ecole d’Economie de Paris et du laboratoire ALISS d’Ivry-sur-Seine ont voulu en savoir plus et comprendre en détail le fonctionnement de ces taxes. Ils se sont intéressés pour cela au cas français.
En un mot
> ZOONOSE : maladie infectieuse causée par une bactérie, un virus ou un parasite, qui se transmet entre l’animal et l’Homme
> ANTHROPOZOONOSE : maladies communes aux humains et aux animaux (mammifères).Les réservoirs principaux sont les rongeurs sauvages (porteurs sains), puis les chiens et les animaux de rente (porcs, chevaux,bovins...).
> ANTIBIORESISTANCE : capacité d'un microorganisme à résister aux effets des antibiotiques
> EPIZOOTIE : épidémie qui touche les animaux